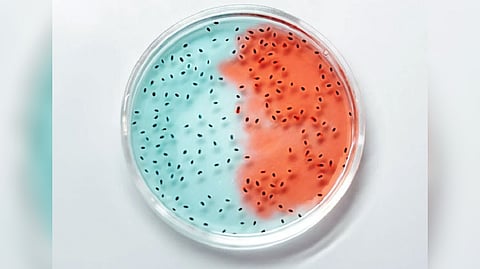
Representative image

WASHINGTON: Even though social ties are essential for the health and well-being of social animals like humans and other primates, there is growing evidence that the gut microbiome, through the so-called "gut-brain axis," is similarly vital for both our physical and mental wellbeing. Additionally, these bacteria can transmit interpersonally, for example by touch.
So how does social connectedness translate into the composition and diversity of the gut microbiome? That's the topic of a new study in Frontiers in Microbiology on rhesus macaques, Macaca mulatta.
Lead author Dr Katerina Johnson, a research associate at the Department of Experimental Psychology and the Department of Psychiatry of the University of Oxford, said: "Here we show that more sociable monkeys have a higher abundance of beneficial gut bacteria, and a lower abundance of potentially disease-causing bacteria."
Monkey island
The scientists focused on a single social group (with 22 males and 16 females between the ages of six and 20 years) of rhesus macaques on the island of Cayo Santiago, off the eastern coast of Puerto Rico. Macaques originally only lived in North Africa and Asia. But in 1938, a founder population of 409 rhesus macaques was moved from India to Cayo Santiago. Today, more than 1,000 macaques live on the 15.2 hectare island, divided into several social groups.
They range and forage freely, although their diet gets supplemented daily with monkey chow. Researchers do behavioral observations on the monkeys each year.
Between 2012 and 2013, the authors collected a total of 50 uncontaminated stool samples from this social group. As a measure of social connectedness, they used the time each monkey spent grooming or being groomed in 2012 and 2013, and his or her number of grooming partners.
Social grooming
Co-author Dr Karli Watson, from the Institute of Cognitive Science at the University of Colorado Boulder, explained: "Macaques are highly social animals and grooming is their main way of making and maintaining relationships, so grooming provides a good indicator of social interactions."
Johnson, Watson et al. analyzed DNA sequence data from the stool samples to measure the composition and diversity of the gut microbial community, and looked at the relationship with social connectivity. They also took into account sex, age, season, and rank within the group's hierarchy. They focused on microbes that have been repeatedly shown in to be either more or less abundant in people or rodents with autism-like symptoms (commonly accompanied by social disconnection) or which are socially deprived.
Sociable monkeys have more 'good' microbes
"Engagement in social interactions was positively related to the abundance of certain gut microbes with beneficial immunological functions, and negatively related to the abundance of potentially pathogenic members of the microbiota," said co-author Dr Philip Burnet, a professor from the Department of Psychiatry at the University of Oxford.
For example, genera more abundant in the most sociable monkeys included Faecalibacterium and Prevotella. Conversely, the genus Streptococcus, which in humans can cause diseases such as strep throat and, pneumonia, was most abundant in less sociable monkeys.
"It is particularly striking that we find a strong positive relationship between the abundance of the gut microbe Faecalibacterium and how sociable the animals are. Faecalibacterium is well known for its potent anti-inflammatory properties and is associated with good health," said Johnson.
Cause and effect?
But what drives the relationship between social connectedness and gut microbiome composition? Distinguishing between cause and effect isn't easy. "The relationship between social behavior and microbial abundances may be the direct result of social transmission of microbes, for example through grooming. It could also be an indirect effect, as monkeys with fewer friends may be more stressed, which then affects the abundance of these microbes. As well as behavior influencing the microbiome, we also know it is a reciprocal relationship, whereby the microbiome can in turn affect the brain and behavior," said Johnson.
Co-author Dr Robin Dunbar, a professor from the Department of Experimental Psychology at the University of Oxford, said: "As our society is increasingly substituting online interactions for real-life ones, these important research findings underline the fact that as primates, we evolved not only in a social world but a microbial one as well."
Visit news.dtnext.in to explore our interactive epaper!
Download the DT Next app for more exciting features!
Click here for iOS
Click here for Android